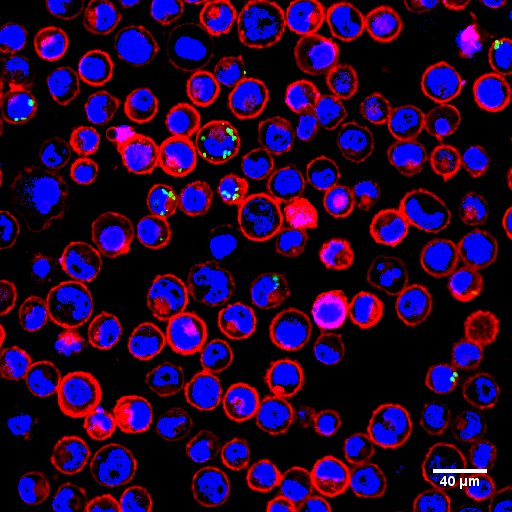

Regeneus Ltd
@regeneus
A regenerative medicine company using stem cell therapies with a focus on osteoarthritis and other musculoskeletal diseases, neuropathic pain and dermatology
ID: 310748408
http://www.regeneus.com.au 04-06-2011 08:41:04
498 Tweet
638 Takipçi
142 Takip Edilen



Meet Dr. Cindy Shu who joins $RGS from University of Sydney's Kolling Institute as part of the MTPConnect #REDI Fellowship Grant. Dr. Shu's expertise in OA pathophysiology, animal models & immune cell analysis will support the Progenza™ clinical program. #regenmed bit.ly/30ctsfy


Australia's #regenmed landscape is rapidly evolving with the opportunity to become a global sector leader. In fact, AusBiotech suggests the success of Australia's regenerative medicine sector could be worth at least $6 billion in annual revenue. Read: bit.ly/3kDm9V0


$RGS is on track to fulfil its obligations and earn future milestone payments and royalties under our agreement with KYOCERA Global in Japan. Hear more from Regeneus CEO Karolis Rosickas on the Company's strategy for Progenza™ in Japan: youtu.be/BmzJ56QN0wk





There is a strong focus on Australia's regenerative medicine future in the latest edition of AusBiotech's Journal. Read pages 60-62 to see why we are so excited to be part of the sector that's developing groundbreaking therapies for patients. #regenmed #industrytrends $RGS










During her studies, Dr. Zheng collaborated closely with industry partner Regeneus Ltd and received guidance from her co-supervisors: Associate Professor Tracy Heng, Professor Laurence Meagher from Monash University, and Professor Graham Vesey from Regeneus.